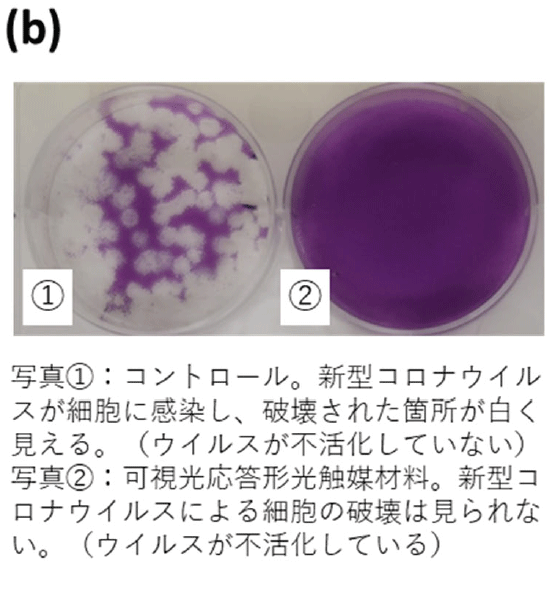
（b）ウイルス感染評価結果の一例。写真1：コントロール。新型コロナウイルスが細胞に感染し、破壊された箇所が白く見える（ウイルスが不活化していない）。写真2：可視光応答型光触媒材料。新型コロナウイルスによる細胞の破壊は見られない（ウイルスが不活化している）。

東工大ニュース
東工大ニュース
公開日:2020.10.05
東京工業大学(物質理工学院 材料系 宮内雅浩教授)、奈良県立医科大学(微生物感染症学講座 中野竜一准教授)、神奈川県立産業技術総合研究所(研究開発部 抗菌・抗ウイルス研究グループ)の研究グループは世界で初めて可視光応答形光触媒材料(CuxO/TiO2)による新型コロナウイルスの不活化を確認しました。その不活化条件を実験的に明示することにより、光触媒による抗ウイルス効果を学問的に示しました。
新型コロナウイルスの感染拡大防止として、様々な場所を使用した後には手作業によるアルコール拭き等が行われており、大変な労力と時間がかかっていました。この課題を解決する手段として、オゾンガスの利用などが実験的に明らかとなっています。しかし、これらは即効性があるものの持続的な抗ウイルス効果を保つ方法ではないため、持続性を持つ材料による新型コロナウイルスへの効果を学問的に確認する必要があります。
東京工業大学及び神奈川県立産業技術総合研究所は東京大学と共同で国立研究開発法人新エネルギー・産業技術総合開発機構(NEDO)の「循環社会構築型光触媒産業創成プロジェクト」(PL:橋本和仁教授(現NIMS理事長))において、非常に高い抗ウイルス効果を持つ可視光応答形光触媒材料[用語1]の開発に成功しています。この光触媒材料は酸化チタンと酸化銅からなり(CuxO/TiO2[用語2])、可視光照射下のみならず光のない状況においても、高い抗ウイルス効果を持つことをすでに報告しています[参考文献1-2]。今回の新型コロナウイルスによる評価結果でも、暗所ならびに日常空間で得られる光照射(1000 lux)でウイルスが不活化されることが判明し、感染拡大防止の一助となりうることが明らかとなりましたので報告します。
可視光応答形光触媒による抗ウイルス性能評価試験として、JIS R 1756が制定されています。今回はその試験方法を参考にした試験を行いました。
新型コロナウイルス株を培養し、安全キャビネット内に設置した試験片(CuxO/TiO2粉体をガラスに担持)に対して、実験対象の新型コロナウイルスを接種します。その後、1000 luxの可視光照射(400 nm以下の紫外光をカットした白色蛍光灯を照射)を行いました。また、光触媒としての効果を確認するため、光の当たらない暗所条件での試験も行いました。一定時間経過後にウイルスを回収し、宿主細胞に接種、ウイルスが細胞に感染しているかを判定して、ウイルス量を算出しました。
本光触媒材料に光照射をすることで、1時間で2.5桁のウイルス量の減少(99.7%の減少)、2時間で検出限界以下である99.99%以上のウイルス量が減少しました。また、暗所においても4時間で検出限界以下に減少させることを明らかにしました。このことから、本光触媒材料を利用することで、新型コロナウイルスを不活化できることがわかりました。本研究成果をもとに、学校、病院やその他多くの人が利用する公共施設等における飛沫の付着や人が触れる場所に対して、持続的な抗ウイルス効果を付与させることが可能になると考えられます。

図. ウイルス量の変化(a)とウイルス感染評価結果の一例(b)。
用語説明
[用語1] 可視光応答形光触媒 : 可視光を吸収して表面に強い酸化力が生じ、接触するニオイ成分や有害物質などを酸化分解する物質。
[用語2] CuxO/TiO2 : 酸化銅と二酸化チタンの複合体で、CuxOのナノ粒子がTiO2の表面に担持されている。CuxOのxは、1<x<2の範囲をとり、銅の1価と2価の混合状態で存在する。
[1] Masahiro Miyauchi, Kayano Sunada, Kazuhito Hashimoto, "Antiviral Effect of Visible Light-Sensitive CuxO/TiO2 Photocatalyst", Catalysts 10 (9), 1093, 2020. (DOI: 10.3390/catal10091093 )
[2] Masahiro Miyauchi, Hiroshi Irie, Min Liu, Xiaoqing Qiu, Huogen Yu, Kayano Sunada, Kazuhito Hashimoto, "Visible-light-sensitive Photocatalysts: Nanocluster-grafted Titanium Dioxide for Indoor Environmental Remediation", J. Phys. Chem. Lett. 7, 75-84, 2016. (DOI: 10.1021/acs.jpclett.5b02041 )
お問い合わせ先
東京工業大学 物質理工学院 材料系
教授 宮内雅浩
E-mail : mmiyauchi@ceram.titech.ac.jp
取材申し込み先
東京工業大学 総務部 広報課
E-mail : media@jim.titech.ac.jp
Tel : 03-5734-2975 / Fax : 03-5734-3661
奈良県立医科大学 研究推進課 阪田・澤井
Tel : 0744-22-3051(内線2552)